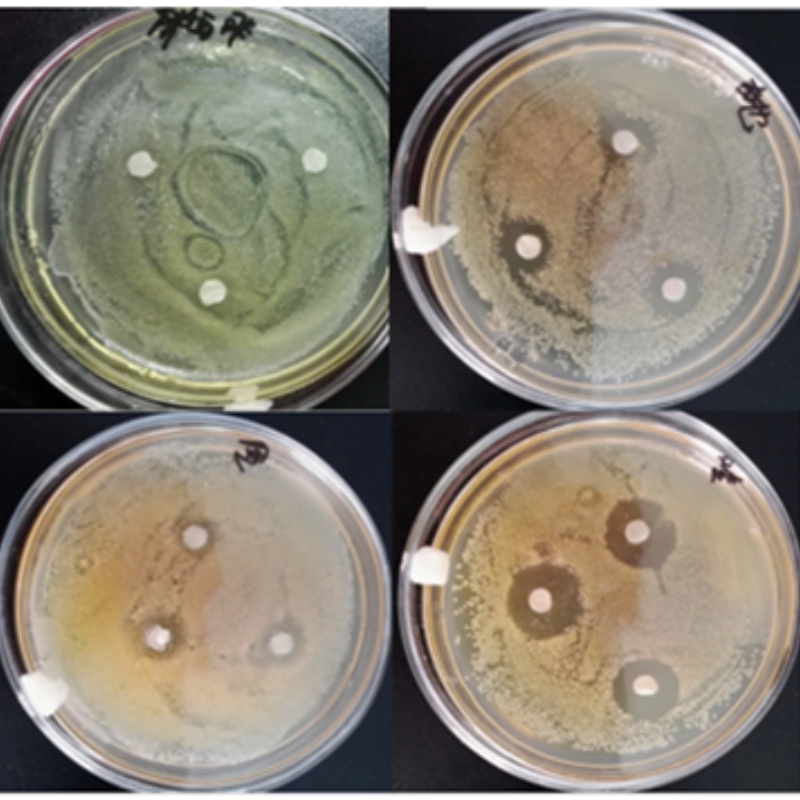
Elevate Growth, Support Immunological Balance, Clostridium Butyricum Food, Infused Probiotic Nutrition
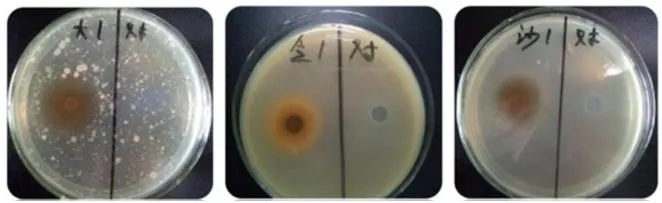
Antibacterial Research

Clostridium Butyricum is a strictly anaerobic endospore-forming Gram-positive butyric acid-producing bacillus. As a common human and animal gut commensal bacterium, it acts as a powerful probiotic. It serves as a potential alternative to antibiotics for managing non-antimicrobial induced diarrhea, constipation, and irritable bowel syndrome.
This product produces short-chain fatty acids (SCFAs), primarily butyrate and acetate, through the fermentation of undigested carbohydrates. Butyrate provides essential energy for colonic epithelial cells, maintains gut immunological homeostasis, and exerts significant anti-inflammatory effects.
| Specification | CB50 | CB100 |
|---|---|---|
| Viable count (CFU/g) | 5 billion (5.0x10^9) | 10 billion (1.0x10^10) |
| Recommended dosage | 200 g/ton | 100 g/ton |
| Form & Odor | Powder / Slight fermentation odor | Powder / Slight fermentation odor |
Applications: Feed Additives, Aquaculture (Shrimp/Fish), and Poultry/Animal Farming (Broilers/Swine).

Conclusion: Application on broilers significantly increases feed conversion rate and reduces mortality.


| Parameter | Standard Limit |
|---|---|
| Arsenic (As) | ≤2 mg/kg |
| Plumbum (Pb) | ≤5 mg/kg |
| Mercury (Hg) | ≤0.1 mg/kg |
| Cadmium (Cd) | ≤0.5 mg/kg |
| Coli group | ≤100 CFU/g |
| Salmonella | None/25g |
| Pathogenic bacteria | Negative |


